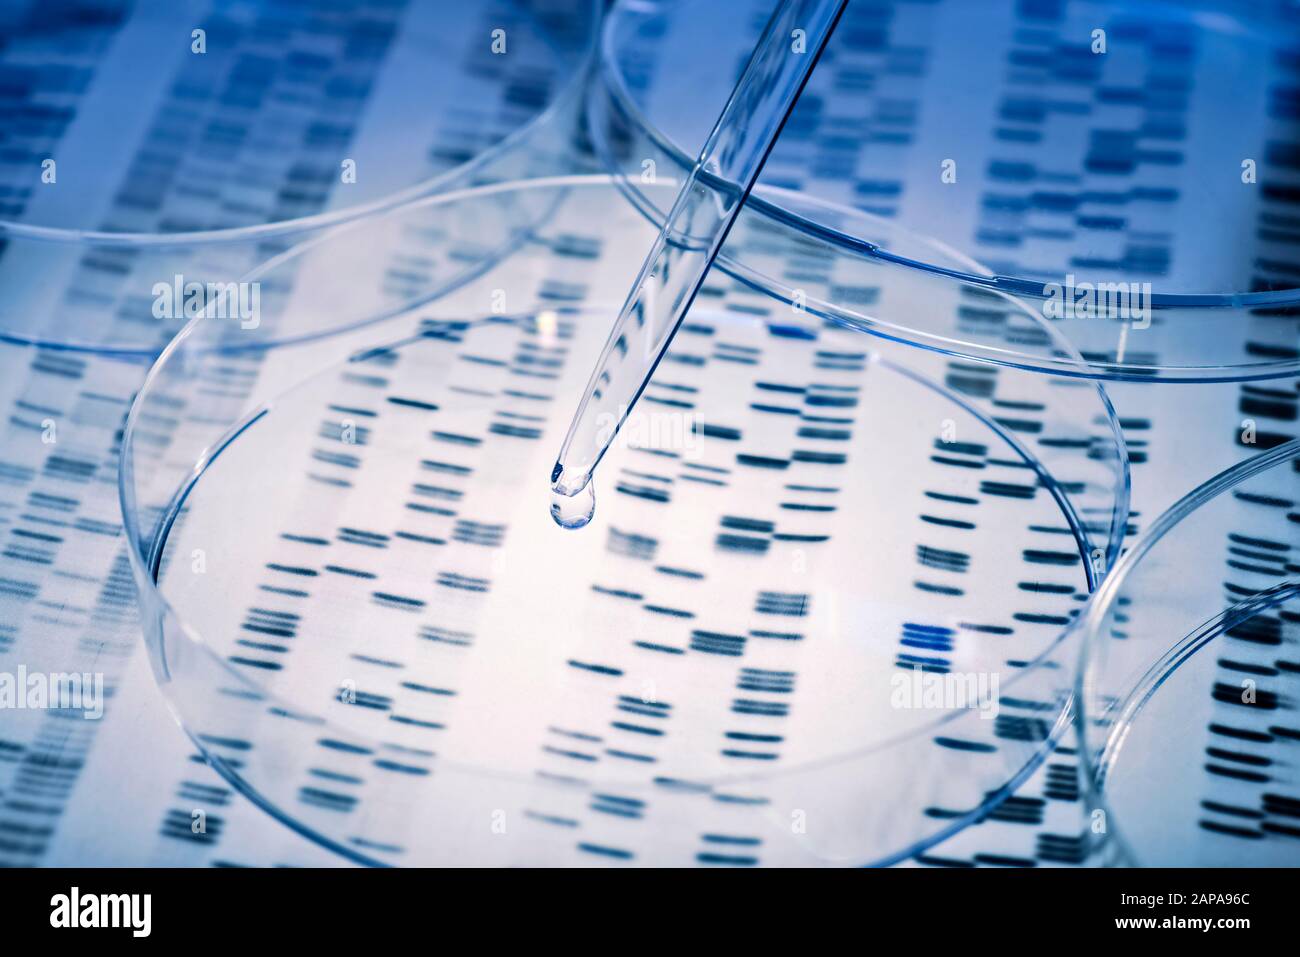
L'échantillon est pipeté dans un plat de Petri sur les résultats génétiques. Banque D'Images

Petri dish Photos Stock & Des Images
(9)Petri dish Photos Stock & Des Images
 Avec une pipette, déposer sur une boîte de pétri. Banque D'Imageshttps://www.alamyimages.fr/image-license-details/?v=1https://www.alamyimages.fr/photo-image-avec-une-pipette-deposer-sur-une-boite-de-petri-165760781.html
Avec une pipette, déposer sur une boîte de pétri. Banque D'Imageshttps://www.alamyimages.fr/image-license-details/?v=1https://www.alamyimages.fr/photo-image-avec-une-pipette-deposer-sur-une-boite-de-petri-165760781.htmlRFKHK1FW–Avec une pipette, déposer sur une boîte de pétri.
 Pipette et boîte de Pétri avec ADN et formules à base scientifique abstraite Banque D'Imageshttps://www.alamyimages.fr/image-license-details/?v=1https://www.alamyimages.fr/pipette-et-boite-de-petri-avec-adn-et-formules-a-base-scientifique-abstraite-image459480134.html
Pipette et boîte de Pétri avec ADN et formules à base scientifique abstraite Banque D'Imageshttps://www.alamyimages.fr/image-license-details/?v=1https://www.alamyimages.fr/pipette-et-boite-de-petri-avec-adn-et-formules-a-base-scientifique-abstraite-image459480134.htmlRF2HKF3GP–Pipette et boîte de Pétri avec ADN et formules à base scientifique abstraite
 Scène de laboratoire avec la pipette et pétri dans la lumière bleue Banque D'Imageshttps://www.alamyimages.fr/image-license-details/?v=1https://www.alamyimages.fr/photo-image-scene-de-laboratoire-avec-la-pipette-et-petri-dans-la-lumiere-bleue-160606707.html
Scène de laboratoire avec la pipette et pétri dans la lumière bleue Banque D'Imageshttps://www.alamyimages.fr/image-license-details/?v=1https://www.alamyimages.fr/photo-image-scene-de-laboratoire-avec-la-pipette-et-petri-dans-la-lumiere-bleue-160606707.htmlRFK987DR–Scène de laboratoire avec la pipette et pétri dans la lumière bleue
 Avec une pipette, déposer et pétri. Banque D'Imageshttps://www.alamyimages.fr/image-license-details/?v=1https://www.alamyimages.fr/photo-image-avec-une-pipette-deposer-et-petri-88921546.html
Avec une pipette, déposer et pétri. Banque D'Imageshttps://www.alamyimages.fr/image-license-details/?v=1https://www.alamyimages.fr/photo-image-avec-une-pipette-deposer-et-petri-88921546.htmlRFF4JM9E–Avec une pipette, déposer et pétri.
L'échantillon est pipeté dans un plat de Petri sur les résultats génétiques. Banque D'Imageshttps://www.alamyimages.fr/image-license-details/?v=1https://www.alamyimages.fr/l-echantillon-est-pipete-dans-un-plat-de-petri-sur-les-resultats-genetiques-image340746180.html
L'échantillon est pipeté dans un plat de Petri sur les résultats génétiques. Banque D'Imageshttps://www.alamyimages.fr/image-license-details/?v=1https://www.alamyimages.fr/l-echantillon-est-pipete-dans-un-plat-de-petri-sur-les-resultats-genetiques-image340746180.htmlRF2APA96C–L'échantillon est pipeté dans un plat de Petri sur les résultats génétiques.
 L'échantillon est pipeté dans un plat de Petri sur les résultats génétiques. Banque D'Imageshttps://www.alamyimages.fr/image-license-details/?v=1https://www.alamyimages.fr/l-echantillon-est-pipete-dans-un-plat-de-petri-sur-les-resultats-genetiques-image340746597.html
L'échantillon est pipeté dans un plat de Petri sur les résultats génétiques. Banque D'Imageshttps://www.alamyimages.fr/image-license-details/?v=1https://www.alamyimages.fr/l-echantillon-est-pipete-dans-un-plat-de-petri-sur-les-resultats-genetiques-image340746597.htmlRF2APA9N9–L'échantillon est pipeté dans un plat de Petri sur les résultats génétiques.
 L'échantillon est pipeté dans un plat de Petri sur les résultats génétiques. Banque D'Imageshttps://www.alamyimages.fr/image-license-details/?v=1https://www.alamyimages.fr/l-echantillon-est-pipete-dans-un-plat-de-petri-sur-les-resultats-genetiques-image340746139.html
L'échantillon est pipeté dans un plat de Petri sur les résultats génétiques. Banque D'Imageshttps://www.alamyimages.fr/image-license-details/?v=1https://www.alamyimages.fr/l-echantillon-est-pipete-dans-un-plat-de-petri-sur-les-resultats-genetiques-image340746139.htmlRF2APA94Y–L'échantillon est pipeté dans un plat de Petri sur les résultats génétiques.

